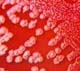

The other day I passed by a cashier at a department store whose telephone, for some reason, wasn't working. He was trying to convince a customer that the problem wasn't caused by
"the Year virus that's going to ruin all our computers."
Funny computers & technical jokes
Funny computers & technical jokes
The other day I passed by a cashier at a department store whose telephone, for some reason, wasn't working. He was trying to convince a customer that the problem wasn't caused by
"the Year virus that's going to ruin all our computers."
These jokes are all in the public domain. Please Respect Copyright Laws.
Leo horoscope
There a lots of sweet delights in the air today, especially if a trip to the sweet shop is in the offing. And if not,......
Full horoscope Titanic Wreck Scanned, Celine Dion Weeps With Envy
Titanic Wreck Scanned, Celine Dion Weeps With Envy
 George W Bush to Take Over as the New Host of The Price is Right and Finally Find the Weapons of Mass Destruction
George W Bush to Take Over as the New Host of The Price is Right and Finally Find the Weapons of Mass Destruction